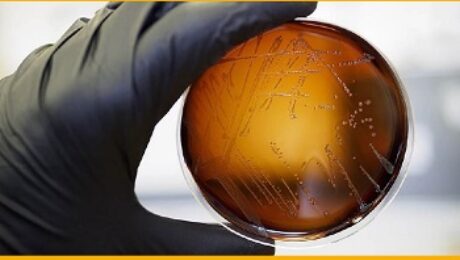

Union de Mutuas pone en marcha la Unidad de Medicina Hiperbarica en su hospital de Castellon
Fuente: UNION DE MUTUAS Mediante la camara hiperbarica se incrementa el oxigeno en sangre y se agilizan los procesos de recuperacion de los pacientes Unión de Mutuas acaba de poner en marcha, en su centro hospitalario de Castellón, la Unidad de Medicina Hiperbárica, una terapia no invasiva, sin efectos secundarios, por el que los pacientes,
- Published in Actualidad
Traumatologos y enfermeros de todo el pais conocen los ultimos avances en artroscopia de hombro
Fuente: MAZ Mas de 130 profesionales de ambas disciplinas se han dado cita en el Hospital MAZ de Zaragoza hasta este sabado El Hospital MAZ de Zaragoza ha sido la sede del V Curso Básico Teórico-Práctico de Artroscopia de Hombro para Enfermería y Traumatología, organizado por Smith&Nephew y Mutua MAZ. Esta cita, que se celebró
- Published in Actualidad
MC Mutual organiza una jornada sobre la prevencion de la zoonosis laboral
Fuente: MC MUTUAL La mutua reunira a distintos especialistas que analizaran los riesgos que conllevan los puestos de trabajo en contacto con animales y sus productos. La globalización y la emergencia de nuevas enfermedades han provocado que, en los últimos años, se haya producido un incremento de los casos de zoonosis, es decir, aquellas enfermedades
- Published in Actualidad
Mutua Montanesa lanza su nueva plataforma online de contratacion publica para ofrecer mayor facilidad y transparencia
Fuente: MUTUA MONTANESA Mutua Montanesa acaba de poner en funcionamiento en su web la nueva plataforma de Contratacion Publica. Con la publicación de su información en el portal https://licitaciones.mutuamontanesa.es/portal, Mutua Montañesa asegura la transparencia y el acceso público a la información relativa a toda su actividad contractual. Así, los usuarios y empresas podrán acceder a
- Published in Actualidad
Houston!! Tenemos un problema, los ciberataques!
Fuente: MAZ Bajo lemas como Houston!! No queremos problemas! o Dale un click a la ciberseguridad!, mutua MAZ quiere distribuir tips entre los trabajadores con informacion, habitos y herramientas sobre como actuar ante posibles ciberataques MAZ, mutua colaboradora con la Seguridad Social nº 11, celebra estos días su Semana de la Ciberseguridad. Durante cinco jornadas
- Published in Actualidad
El foro de RRHH que organizan MAC y el grupo Preving retoma su actividad con la charla -La era del talentismo-
Fuente: MAC Organizado por la Mutua de Accidentes de Canarias (MAC) y PREVIMAC El CEO de VALTIA y UEBOS Comunicación, Agoney Melián, también presidente de Jóvenes Empresarios de Tenerife (JET), se refirió hoy, en el transcurso de su ponencia “La era del talentismo”, al muchas veces controvertido significado del concepto éxito. Melián, dentro de esta
- Published in Actualidad